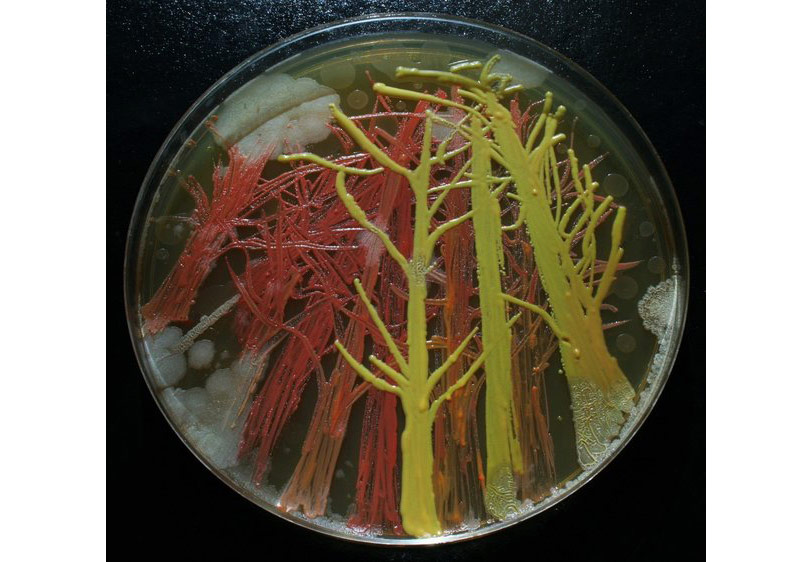
Ressam Bakteriler

Merhaba !
Üye ol ve keşfe başla.
Artfulliving.com.tr sizin için sanat ve kültür yaşamın günlüğünü tutar, öne çıkan eserleri, sanatçıları paylaşır. Koleksiyonunuza eklemek istediğiniz heyecan verici bir eseri incelemeniz, yeni öncü sanatçılar ile tanışmanız, eserlerinizi tüm dünya ile paylaşmanız mümkün.


02 AĞUSTOS, SALI, 2016
Ressam Bakteriler
İspanyol sanatçı Maria Peñil Cobo doğadan ilham alıyor. Fakat sanatçı geniş ormanlar ya da engin okyanuslar yerine daha küçük ekosistemlere ve bakterilere odaklanıyor.
Mikrobiyolog doktor Mehmet Berkmen ile beraber beş yıl boyunca renkli bakteriler üzerine çalışan Cobo, bu mikropları büyüleyici sanat eserlerine dönüştürüyor.
Tuval olarak bakteri kaplarını kullanan sanatçıya bakterileri nasıl kullanacağını Berkmen öğretmiş. Kullanılan her bakterinin türü farklı olduğundan, bazıları hemen renklenirken bazıları yaşlandıkça renk alıyor.
800 Karakter ile sınırlıdır.
NELER OLUYOR
29-04-2026
27-04-2026
09-04-2026